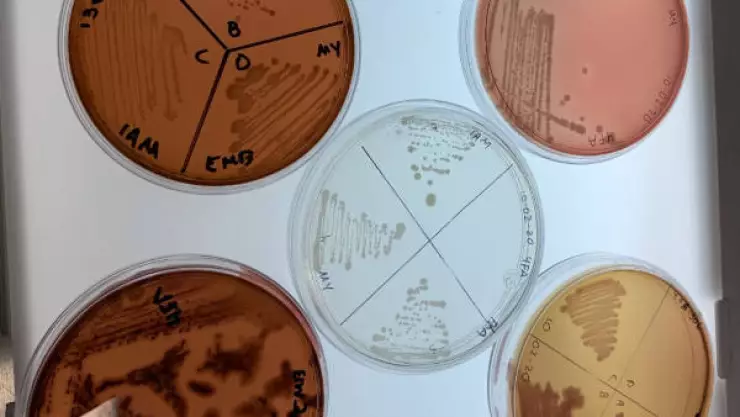
Bacterias servirían suelos dañados por hidrocarburos

Científicos del Centro de Biotecnología Genómica del IPN descubrieron bacterias capaces de degradar hidrocarburos en suelos, cuyo potencial biológico abre la posibilidad de emplearlos en la biorremediación para la recuperación de superficies altamente contaminadas.
El proyecto de investigación lo dirige la doctora María Antonia Cruz, quien explicó que cuenta con una colección de cepas aisladas de suelos contaminados, pero sobresale la actividad de la bacteria Sphingobium yanoikuyae, que ha mostrado su potencial en procesos de degradación de hidrocarburos como: Tolueno, naftaleno, fenantreno y xileno, mientras que la bacteria Microbacterium petrolearium degrada petróleo crudo ligero.
La especialista del Laboratorio de Interacción Ambiente Microorganismo del Centro precisó que las cepas encontradas fueron aisladas de suelos contaminados y aunque hasta ahora han observado la capacidad de degradación que tienen ambas, aún hace falta evaluar a estas cepas en consorcio, a fin de comprobar si su actividad se potencializa.
Añadió que también estudian otros microorganismos para conformar consorcios que mejoren el proceso de degradación.
La doctora Cruz Hernández comentó que su equipo de trabajo cuenta con una colección de cepas aisladas de zonas áridas de una Rizobacteria promotora del crecimiento vegetal denominada Azospirillum brasilense, y al secuenciar el genoma de una de ellas encontraron genes relacionados con degradación de xenobióticos pesticidas, hidrocarburos y detergentes.
Por ello, indicó, se intensificarán estos estudios y más adelante los investigadores podrían considerar incorporarla a los ensayos de biorremediación.